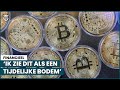
'Rode crypto-koersen als renteverhoging aanblijft'

Beursspel TV (afl.12): 'Ook als koersen dalen, zijn er koopkansen' #Beursspel2022
Nieuws per site:
NL sectie's:
Beursspel TV (afl.12): 'Ook als koersen dalen, zijn er koopkansen' #Beursspel2022 - RTL Z
Persoonlijke sites:
Geen persoonlijke sites
Actueel Nieuws:
Voetbal nieuws:
Eredivisie:
Voetbal nieuws:
Premier League (Engeland!)
Primera División (Spanje!)
Serie A (Italië!)
Ligue 1 (Frankrijk!)
Jupiler Pro League (België!)
Overige Sporten:
Sport Nieuws (algemeen)
Gaming:
Politiek:
Bedrijven:
Computer, Gadgets & Internet:
Algemeen Nieuws:
TV / Media / Muziek:
Landen / Gebieden:
Provincies:
Steden:
Steden buitenland:
Overige Subsectie's:
En verder...
Copyright © 2001-2026 - Headliner.nl - Content & Design: Splendense - cookie instellingen - privacy policy
Beursspel TV (afl.12): 'Ook als koersen dalen, zijn er koopkansen' #Beursspel2022 Headliner: Het laatste en meeste Beursspel TV (afl.12): 'Ook als koersen dalen, zijn er koopkansen' #Beursspel2022 verzameld!